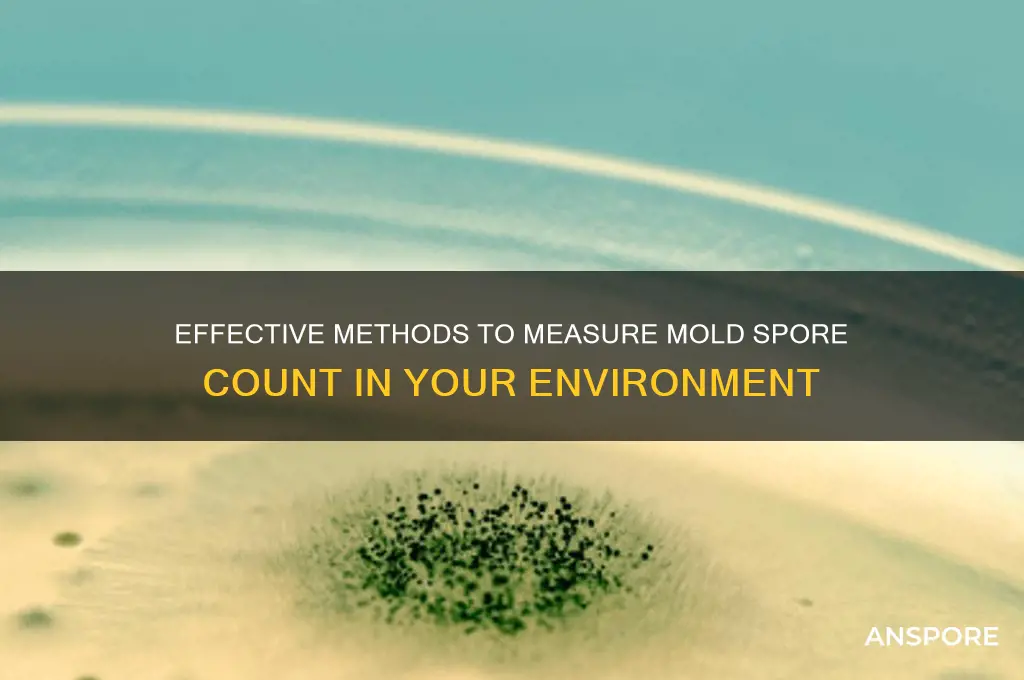
how to get a mold spore count

Obtaining a mold spore count is a critical step in assessing indoor air quality and identifying potential mold issues in homes, workplaces, or other environments. This process typically involves using specialized equipment, such as an air sampling pump and spore trap, to collect airborne mold particles from a designated area. The collected samples are then analyzed under a microscope or sent to a laboratory for detailed identification and quantification of mold spore types and concentrations. Understanding the spore count helps determine the severity of mold contamination, potential health risks, and the necessary remediation steps. Proper sampling techniques, including selecting appropriate locations and times for testing, are essential to ensure accurate and reliable results.
| Characteristics | Values |
|---|---|
| Method | Air Sampling, Surface Sampling, Bulk Sampling |
| Tools Required | Air Pump, Spore Trap Cassettes, Swabs, Microscope, Petri Dishes |
| Sampling Duration | 5-15 minutes for air sampling (depends on device) |
| Sampling Locations | Indoor air, HVAC systems, surfaces, walls, carpets |
| Laboratory Analysis | Microscopic examination, Culture-based methods, PCR (DNA analysis) |
| Units of Measurement | Spores per cubic meter (spores/m³) for air, CFU/swab for surfaces |
| Threshold Levels | Varies by region; e.g., WHO recommends <1,000 spores/m³ for indoor air |
| Cost | $100-$500 for DIY kits; $300-$1,000+ for professional testing |
| Turnaround Time | 24-72 hours for lab results |
| Accuracy | Depends on method; PCR is most accurate, followed by microscopy |
| Common Mold Types Detected | Aspergillus, Penicillium, Cladosporium, Stachybotrys (black mold) |
| Regulatory Standards | OSHA, EPA, WHO guidelines for acceptable spore counts |
| DIY vs. Professional | DIY kits are less accurate; professionals ensure proper sampling |
| Precautions | Wear PPE (gloves, masks) during sampling; avoid disturbing mold |
| Applications | Indoor air quality assessment, post-remediation verification |
| Limitations | Cannot identify viable vs. non-viable spores in all methods |
Explore related products
What You'll Learn
- Sampling Methods: Swab, tape lift, air pump, bulk collection, and dust sampling techniques for mold spores
- Equipment Needed: Tools like spore traps, microscopes, and air pumps for accurate mold spore counts
- Testing Locations: Identify high-risk areas like basements, bathrooms, and attics for mold spore sampling
- Lab Analysis: Send samples to labs for microscopic or culture-based mold spore identification and counting
- Interpreting Results: Understand spore count thresholds and health risks associated with mold levels

Sampling Methods: Swab, tape lift, air pump, bulk collection, and dust sampling techniques for mold spores
Mold spore counts are essential for assessing indoor air quality and identifying potential health risks. Among the various sampling methods, swab sampling stands out for its simplicity and directness. This technique involves using a sterile swab to collect mold spores from surfaces like walls, countertops, or furniture. Moisten the swab with a sterile solution (e.g., distilled water or phosphate buffer) to ensure spores adhere effectively. Gently rub the swab in a zigzag pattern over a 10 cm x 10 cm area, then place it in a sterile container for lab analysis. Swab sampling is ideal for visible mold growth but may miss spores embedded deeply in porous materials. Its low cost and ease of use make it a go-to method for preliminary assessments, though it’s less effective for airborne spore detection.
In contrast, tape lift sampling offers a non-invasive way to collect mold spores from surfaces without damaging the material. Apply a piece of clear adhesive tape (e.g., cellophane or Scotch tape) to the suspected area, press firmly, and lift it off. The spores adhere to the tape, which is then placed on a microscope slide for direct examination or sent to a lab. This method is particularly useful for identifying mold types on delicate surfaces like wallpaper or painted walls. However, it’s limited to surface-level spores and may not capture sufficient quantities for accurate quantification. Tape lifts are best paired with other methods for comprehensive analysis, especially in environments with hidden or widespread mold.
For airborne mold spore detection, air pump sampling is the gold standard. This method uses a calibrated air pump to draw a known volume of air (typically 75 liters or more) through a spore trap, such as a cassette with a sticky surface or a filter. The spores are captured and later analyzed in a lab to determine their concentration and type. Air sampling is critical for assessing indoor air quality and identifying hidden mold sources. However, it requires specialized equipment and precise calibration to ensure accurate results. Factors like sampling duration (15 minutes to several hours) and placement of the pump (1 meter above the floor, away from walls) significantly influence outcomes. This method is indispensable for professional mold inspections but may be overkill for casual assessments.
When dealing with larger mold-contaminated materials, bulk collection becomes necessary. This involves physically removing a piece of the affected material (e.g., drywall, carpet, or insulation) and sending it to a lab for analysis. Bulk sampling is straightforward and provides a clear picture of mold colonization within the material. However, it’s destructive and may not represent the entire area if mold growth is uneven. Labs typically weigh the sample, process it to release spores, and analyze them microscopically. This method is cost-effective for confirming mold presence in specific materials but doesn’t measure airborne spores, making it a complementary technique rather than a standalone solution.
Finally, dust sampling offers a unique perspective by analyzing settled mold spores in household dust. Collect dust from surfaces like floors, vents, or furniture using a vacuum or damp cloth, then send the sample to a lab. This method reflects long-term mold exposure rather than immediate conditions, making it valuable for health-related assessments. Dust sampling is particularly useful in homes with children or pets, as it identifies cumulative spore levels. However, it doesn’t pinpoint mold sources and may include spores from outdoor dust. Combining dust sampling with air or surface methods provides a holistic view of mold contamination, ensuring no aspect of the environment is overlooked. Each sampling technique has its strengths and limitations, and the choice depends on the specific goals of the mold assessment.
Mastering Spore Editing: A Step-by-Step Guide to Custom Creations
You may want to see also

Equipment Needed: Tools like spore traps, microscopes, and air pumps for accurate mold spore counts
To accurately measure mold spore counts, specialized equipment is essential. Spore traps, for instance, are the cornerstone of this process. These devices capture airborne spores onto a sticky surface or collection medium, allowing for subsequent analysis. The Air-O-Cell and Burkard spore trap are popular choices, each with unique mechanisms suited to different environments. Selecting the right trap depends on factors like airflow, particle size, and the duration of sampling, ensuring that the data collected is both precise and representative of the area tested.
Once spores are captured, a microscope becomes indispensable for identification and quantification. A compound microscope with at least 400x magnification is recommended to distinguish between mold spore types, which vary in size, shape, and texture. For advanced analysis, phase-contrast or fluorescence microscopy can enhance visibility, particularly for smaller or translucent spores. Proper calibration and clean slides are critical to avoid contamination, which could skew results and lead to inaccurate conclusions about mold presence and concentration.
Air pumps are another vital component, driving the airflow necessary to collect spores in the trap. These pumps must deliver a consistent flow rate, typically 10–15 liters per minute, to ensure reliable sampling over a standardized period, often 5 to 15 minutes per location. Portable, battery-operated pumps are ideal for field work, while stationary models are better suited for long-term monitoring in indoor environments. Regular maintenance, such as filter changes and flow rate checks, ensures the pump operates efficiently and does not compromise data integrity.
While these tools are effective, their use requires careful consideration of environmental factors. Humidity, temperature, and air movement can influence spore distribution and trap efficiency. For example, high humidity may cause spores to clump, making them harder to count, while low humidity can reduce spore viability. Sampling should be conducted under stable conditions, and multiple locations within a space should be tested to account for variability. Proper training in equipment handling and data interpretation is also crucial to avoid errors that could lead to costly misdiagnoses or unnecessary remediation efforts.
In conclusion, achieving accurate mold spore counts demands a combination of the right tools and meticulous technique. Spore traps, microscopes, and air pumps form the backbone of this process, each playing a distinct role in capturing, analyzing, and quantifying spores. By understanding the strengths and limitations of these tools and applying them judiciously, professionals can provide reliable assessments of mold levels, guiding informed decisions about indoor air quality and health risks.
Mastering Spore: A Step-by-Step Guide to Creating Custom Themes
You may want to see also

Testing Locations: Identify high-risk areas like basements, bathrooms, and attics for mold spore sampling
Mold spores thrive in damp, dark environments, making certain areas of your home prime candidates for testing. Basements, with their often poor ventilation and susceptibility to water intrusion, are a common hotspot. Look for signs like musty odors, visible water stains, or a history of flooding. Bathrooms, another high-risk zone, provide the perfect combination of moisture and warmth from showers and baths. Pay close attention to areas around tubs, showers, and under sinks where leaks can go unnoticed. Attics, while seemingly dry, can harbor mold due to roof leaks, inadequate insulation, or poor ventilation, creating a hidden breeding ground for spores.
Mastering Mushroom Spore Extraction: A Step-by-Step Guide for Beginners
You may want to see also
Explore related products

Lab Analysis: Send samples to labs for microscopic or culture-based mold spore identification and counting
Mold spore identification and counting through lab analysis is a precise method that leverages advanced techniques to provide detailed insights into mold contamination. Microscopic analysis involves examining samples under a microscope to identify spore types and quantify their presence. This method is quick, typically yielding results within 24 to 48 hours, and is ideal for urgent assessments. Culture-based analysis, on the other hand, cultivates mold spores on growth media to identify species and measure colony-forming units (CFUs). While slower, taking 3 to 7 days, it offers a more comprehensive understanding of viable mold populations, making it suitable for in-depth investigations.
To initiate lab analysis, collect samples using sterile swabs, tape lifts, or air cassettes, ensuring they are uncontaminated. For air samples, follow the manufacturer’s instructions for spore trap devices, typically collecting air volumes of 75 liters or more to ensure accuracy. Surface samples should cover a 100 cm² area to provide a representative snapshot of mold presence. Label all samples clearly with location, date, and time of collection, as these details are critical for accurate interpretation of lab results. Most labs provide sample collection kits with detailed instructions, simplifying the process for non-professionals.
Once collected, samples should be shipped to the lab promptly, ideally within 24 hours, to preserve spore integrity. Use insulated packaging with cold packs for culture-based samples to prevent degradation during transit. Labs employ standardized protocols, such as the EPA’s ERMI (Environmental Relative Moldiness Index) or AIHA (American Industrial Hygiene Association) guidelines, to ensure consistency and reliability in results. Costs vary depending on the method, with microscopic analysis ranging from $50 to $150 per sample and culture-based analysis costing $100 to $300 per sample.
Interpreting lab results requires understanding key metrics. Microscopic analysis reports spore types and concentrations per cubic meter of air or per square centimeter of surface. Culture-based results provide CFU counts and species identification, often with a viability assessment. For context, indoor air spore counts above 1,000 spores/m³ or surface counts exceeding 100 spores/cm² may indicate significant mold issues, though thresholds vary by environment. Labs often include recommendations for remediation based on findings, making this method invaluable for both residential and commercial settings.
While lab analysis is highly accurate, it’s not without limitations. Microscopic methods cannot distinguish between viable and non-viable spores, potentially overestimating risks. Culture-based analysis may underestimate counts if spores are dormant or slow-growing. Combining both methods can provide a more complete picture, though it increases costs. For those seeking cost-effective alternatives, at-home mold test kits are available, but they lack the precision and species identification of lab analysis. Ultimately, lab analysis remains the gold standard for definitive mold spore counting and identification.
Troubleshooting Spore Login Issues: Origin and Steam Fixes Explained
You may want to see also

Interpreting Results: Understand spore count thresholds and health risks associated with mold levels
Mold spore counts are not just numbers—they’re indicators of potential health risks. Understanding thresholds is critical, as levels below 1,000 spores per cubic meter (spores/m³) are generally considered normal outdoor background concentrations. Indoors, however, the acceptable limit drops significantly. The Environmental Protection Agency (EPA) does not set specific thresholds, but many professionals consider indoor counts above 500 spores/m³ as a red flag, especially if specific mold types like *Stachybotrys* (black mold) are present. Context matters: a count of 1,000 spores/m³ in a home with visible mold growth is far more concerning than the same count in a mold-free environment.
Interpreting results requires knowing which molds pose the greatest risks. For instance, *Aspergillus* and *Penicillium* are common indoor molds that can trigger allergies and asthma, particularly in sensitive individuals like children, the elderly, or those with compromised immune systems. *Stachybotrys*, while less common, produces mycotoxins that can cause severe respiratory issues and fatigue. A high count of these specific molds, even at lower overall spore levels, warrants immediate action. For example, a count of 200 spores/m³ of *Stachybotrys* is far more alarming than 1,000 spores/m³ of less harmful molds like *Cladosporium*.
Thresholds are not one-size-fits-all. Factors like humidity, ventilation, and occupant health play a role. In healthcare settings, stricter limits apply—typically below 100 spores/m³—to protect vulnerable patients. Schools and homes with children or asthmatics should aim for counts under 300 spores/m³. Practical tips include comparing indoor and outdoor counts; if indoor levels are consistently higher, it suggests an indoor mold source. Seasonal trends also matter: outdoor counts spike in fall, so elevated indoor levels during other seasons are more concerning.
To mitigate risks, act swiftly if counts exceed thresholds. For counts between 500–1,000 spores/m³, improve ventilation and inspect for moisture sources. Above 1,000 spores/m³, professional remediation is advised, especially if toxic molds are present. Use HEPA filters to reduce airborne spores and monitor humidity levels below 50%. For sensitive populations, even moderate counts (300–500 spores/m³) may require proactive measures like air purifiers or mold-resistant materials.
In summary, interpreting spore counts demands a nuanced approach. Thresholds are starting points, not absolutes. Combine data with visual inspections, occupant health symptoms, and environmental factors to assess risk accurately. Remember, the goal isn’t just to measure mold—it’s to create a safe, healthy space.
Mastering Spore's Skies: Tips to Soar Higher and Explore Further
You may want to see also
Frequently asked questions
A mold spore count measures the number of mold spores in a given area, typically collected through air or surface sampling. It is important because it helps assess indoor air quality, identify mold contamination, and determine potential health risks associated with mold exposure.
To get a mold spore count, hire a certified mold inspector or industrial hygienist to perform air or surface sampling. They will use specialized equipment like spore traps or swabs to collect samples, which are then analyzed in a lab for spore counts and types.
While DIY mold test kits are available, they often lack accuracy and reliability compared to professional testing. For precise spore counts and proper interpretation of results, it’s best to consult a professional.
Factors like weather conditions, ventilation, recent cleaning, and sampling techniques can influence results. Professional testers account for these variables to ensure accurate readings.
If the spore count is elevated, consult a mold remediation specialist to identify and address the source of mold. Take steps to improve ventilation, reduce moisture, and clean affected areas to prevent further growth.































